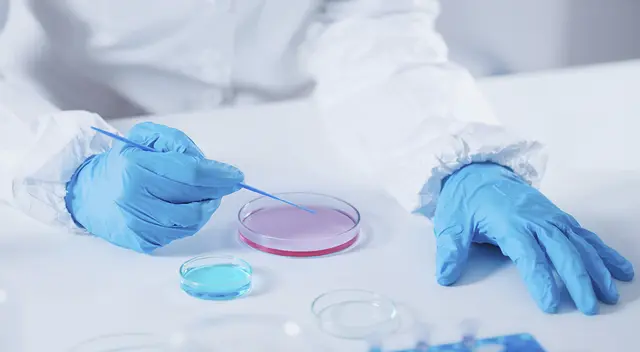
Vacuna oral Vacuna oral

COVID-19: Proponen vacuna oral que soportaría mayores temperaturas
Estudiantes de UTEC buscan financiamiento para una candidata a vacuna que no necesitaría los niveles de ultra refrigeración que otras opciones requieren.
Únete al canal de Whatsapp de El Popular- Chirimoya, la fruta que calma la ansiedad y refuerza tu inmunidad
- El romero y sus increíbles beneficios para el cerebro: mejora tu concentración y memoria
Hasta el momento, los peruanos han recibido casi 10 millones de vacunas contra la COVID-19. Sin embargo, el avance -aunque positivo- sigue siendo desigual a lo largo del país. Esto se debe a que vacunas, como la de Pfizer, requieren ser almacenadas a temperaturas de -70ºC. Para ello, el Centro Nacional de Abastecimiento de Recursos Estratégicos en Salud (CENARES) cuenta con cámaras de ultra refrigeración en Lima, pero no todas las regiones del país tienen esta tecnología a su disposición.
Pensando en este contexto, estudiantes de la Universidad de Ingeniería y Tecnología (UTEC) investigan una candidata a vacuna oral termoestable contra COVID-19, conocida como Lecchain. Esta podría ser transportada y distribuida sin pasar por la compleja y costosa logística de cadena de frío que requieren otras vacunas.
“Muchas vacunas son susceptibles a los cambios de temperatura, lo que representa un reto en su distribución y almacenamiento, especialmente en países como el nuestro, donde el manejo de una cadena de frío de gran nivel es dificultoso y costoso. Se necesita infraestructura especializada, almacenes con control de temperatura y contenedores refrigerados, que no existen en todo el país”, detalla Marcelo Hurtado, coordinador del equipo investigador.
El equipo multidisciplinario de alumnos que realizan el proyecto está conformado por María De Fátima Salazar, Massiel Copara, Ximena Fernández, Marcelo Hurtado, Ariana Villegas, Alessandro Giuffra, Allison Aldoradin, José Cisneros, Gladys Cavero, Nathaly Dongo, Yomali Ferreyra, Valeria Márquez, Diana Peña, Luis Quesada y Amalia Villena. Asimismo, cuentan con el asesoramiento del Dr. Julio Valdivia, director de Bioingeniería de UTEC y del Centro de Investigación en Bioingeniería (BIO), y el Dr. Alberto Donayre, docente de bioingeniería de la casa de estudios.
“En UTEC, creemos que la ingeniería, la tecnología y la investigación tienen un propósito y pueden generar grandes cambios en el mundo. Por ello, nos sentimos muy orgullosos de que nuestros docentes y alumnos desarrollen proyectos innovadores y de alto impacto que sean capaces de resolver las grandes problemáticas del siglo XXI. Así, enfocamos nuestro modelo educativo en llevar el ingenio de nuestros estudiantes a la acción”, afirma Valdivia.
Lecchain puede ser fácilmente reconstituida de su presentación liofilizada, por lo que es congelada previamente para su preservación. De este modo, podría llegar a áreas remotas que no cuentan con la tecnología necesaria para acceder a las otras opciones de vacunas que hoy existen. El objetivo es crear una fórmula innovadora que podrá soportar altas temperaturas sin perder su eficacia. Actualmente, se encuentran en la fase de investigación.
Para continuar con la iniciativa y conseguir el financiamiento necesario para su candidata a vacuna, el equipo de investigación viene participando de una competencia organizada por la International Genetically Engineered Machine (iGEM) Foundation, una de las organizaciones más prestigiosas de Biología Sintética a nivel mundial. También buscan que la entidad privada se una a sus esfuerzos y aporte a la investigación con financiamiento. Pueden contactar al equipo investigador mediante su cuenta de Instagram, Linkedin o al correo igem@utec.edu.pe.
Somos el equipo de Vida de El Popular informando sobre COVID-19, recetas, enfermedades, salud, economía, nutrición, manualidades, belleza, mascotas, psicología y más.












